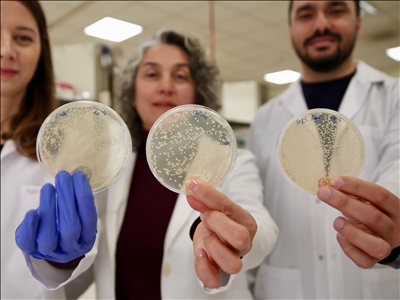

WWF ve Londra Zooloji Derneği (ZSL) tarafından iki yılda bir yayımlanan Yaşayan Gezegen Raporu'nun 15'incisi, geçen hafta kamuoyu ile paylaşıldı.
5 bin 495 türe ait yaklaşık 35 bin popülasyonun 1970-2020 arasındaki durumunu ortaya koyan rapora göre yaban hayatı popülasyonunda en sert düşüş, yüzde 95'le Latin Amerika ve Karayipler'de gözlemlenirken, onu yüzde 76 ile Afrika ve yüzde 60'la Asya-Pasifik bölgeleri takip etti.

Rapora ilişkin AA muhabirinin sorularını yanıtlayan WWF-Türkiye Doğa Koruma Direktörü Güner Ergün, yaban hayatı popülasyonlarındaki düşüşleri, sağlıklı ekosistemlerdeki olası kayıpların erken uyarı işareti olarak nitelendirdi.
Raporun omurgalı hayvan türlerindeki popülasyonlara ilişkin çarpıcı sonuçlar barındırdığını, yaban hayatı popülasyonlarının ortalama büyüklüğünde sadece 50 yıl içinde yüzde 73'lük düşüş görülmesinin de bu sonuçların en çarpıcısı olduğunu belirten Ergün, "Ekosistemlerdeki bu kayıplar aynı zamanda insanın geleceği için de büyük ve önemli tehditler oluşturuyor. En büyük düşüşler tatlı su popülasyonlarında görüldü. Yapılan izleme çalışmaları tatlı su popülasyonlarının yüzde 85 oranında düştüğünü ve bunu yüzde 69 düşüş ile kara ve yüzde 56 düşüş ile deniz ekosistemlerinin takip ettiğini gösteriyor. Eğer popülasyonlardaki düşüşler devam ederse bu, ekosistem hizmetlerinin de görevlerini tamamen yerine getiremeyeceği anlamına gelir. Yani tozlaşmanın ve besin döngüsünün olmadığını düşünün." dedi.

"Gıdamız sera gazı emisyonlarının yüzde 27'sinden sorumlu"
Gıda sistemlerinin biyolojik çeşitliliği etkileyen en önemli faktörlerden biri olduğunu vurgulayan Ergün, sözlerini şöyle sürdürdü:
"Bugün dünya üzerinde yaşanabilir alanların yaklaşık yüzde 40'ı tarım alanı olmuş vaziyette. Bu da yaklaşık 4,2 milyar hektarlık bir alana tekabül ediyor. Bunun içinde hayvan yetiştiriciliği, otlatma gibi faaliyetler de yer alıyor. Gıdamız, sera gazı emisyonlarının bugün yüzde 27'sinden, tatlı su kullanımının ise yüzde 70'inden sorumlu. Aynı zamanda habitatların tahrip edilmesi ve kaybedilmesi nedeniyle kuşlar, memeliler gibi canlıların da özellikle yüzde 86'lık bir kısmının kaybolmasından yani biyolojik çeşitlilik kaybından sorumlu. Bunun için özellikle son zamanlarda iklime uygun tarım ve agroekoloji, onarıcı tarım gibi uygulamalarla bu tahribatlar bertaraf edilmeye çalışılıyor."
Bir ekosistemin geri dönüşü mümkün olmayan büyük ölçekli bir değişim geçirdiği kritik noktaya eşik değeri dendiği bilgisini paylaşan Ergün, Amazonlar'daki yağmur ormanlarının yok olması veya mercan resiflerinin kitlesel olarak ağarması gibi küresel eşik noktalarının, bulundukları çevrenin sınırlarını aşan şok dalgaları oluşturarak tüm dünyada gıda güvenliği ve geçim kaynaklarına ilişkin sorunlara yol açma riski taşıdığını söyledi.

İklim değişikliği ve ormansızlaşma nedeniyle azalan yağış miktarının Amazonlar'daki koşulları elverişsiz hale getireceği ve eşik noktasının aşılabileceği yönündeki kaygıların bilim insanlarınca gündeme getirildiğine değinen Ergün, bu durumun bölgesel ve küresel hava koşullarını değiştirerek Amazonları bir karbon yutağı olmaktan çıkararak bölgenin bir emisyon kaynağı haline gelmesine yol açabileceğini ifade etti.
Eşik noktalarının yerel ve bölgesel düzeylerde olduğu gibi küresel düzeyde de ortaya çıkabildiğini bildiren Ergün, "Kuzey Amerika'da göç yolları üzerindeki barajlardan dolayı göçlerinin engellenmesi nedeniyle Chinook somonu balıkçılığının çöküşü, büyük bariyer setlerindeki mercan adalarının ağarması ve mercan resiflerinin tamamen yok olması önemli eşik noktalarından bazıları. Bunun dışında Afrika'da yasa dışı fil dişi avcılığı nedeniyle fil popülasyonlarının yaklaşık yüzde 80 oranında azalması ve kartal gagalı deniz kaplumbağalarında yine habitat kaybına bağlı olarak popülasyonundaki büyük düşüşler biyolojik çeşitlilikteki en büyük azalmalar." diye konuştu.

"Kirlilik balıkların neslini tehdit ediyor"
Türkiye'nin sulak alan çeşitliliği ve geniş ölçeğiyle, özellikle göçmen kuş türlerine ev sahipliği yapması bakımından bulunduğu coğrafyanın en önemli ülkelerinden biri olduğunu fakat aşırı kullanım, kirlilik ve plansız yapılaşma gibi tehditler ve iklim değişikliğinin de etkisiyle sulak alanlarda su kaybı ve dönemsel kurumalar meydana geldiğini anlatan Ergün, sulak alanların sağlıklı yapılarını kaybetmesinde en önemli faktörlerden birinin, tarımda kullanılan verimsiz sulama yöntemleri olduğunu, kent, sanayi ve tarım kaynaklı kirliliğin sucul türlerin sağlığını olumsuz etkileyerek bazı balık türlerinin neslini tehdit ettiğini dile getirdi.
Gıda sistemlerinin yanı sıra aşırı avlanma, istilacı türler ve hastalıkların da dünya genelinde yaban hayatı popülasyonlarına yönelik tehditler arasında bulunduğunu işaret eden Ergün, "Örneğin Kızıldeniz'den geçen istilacı yabancı türler, Akdeniz'de bugünkü istilacı türlerin 3'te 2'sini oluşturuyor. Bu türlerin sayısı da gün geçtikçe artıyor bugüne kadar tespit edilenlerin sayısı 105'in üzerinde. Bunların içerisinde balıklar, yumuşakçalar, kabuklular gibi canlılar bulunuyor." tespitini paylaştı.

"COP16 ve COP29 ülkelere yeni bir fırsat sunuyor"
Ülkelerin bulunduğu taahhütlerin ve sahada gerçekleştirilen eylemlerin, 2030 hedeflerine ulaşmak ve söz konusu eşiklerin aşılmasından kaçınmak adına yapılması gerekenlerin çok gerisinde olduğunu ve raporda da bu duruma işaret edildiğini belirten Ergün, Kolombiya'nın Cali kentinde başlayan Biyolojik Çeşitlilik Sözleşmesi Taraflar Konferansı (COP16) ve önümüzdeki aylarda gerçekleştirilecek olan BM İklim Zirvesi'nin (COP29) ülkelere, karşı karşıya oldukları zorlukların büyüklüğü ile orantılı hamleler yapmak için yeni bir fırsat sunduğunun altını çizdi.
Devletlerin ve özel sektörün, biyoçeşitlilik ve iklim üzerinde olumsuz etkileri olan faaliyetlere hızla son vermek için harekete geçmesi ve acilen gezegeni krize sürükleyen uygulamalara harcanan kaynakları, küresel hedeflere ulaşmayı sağlayacak faaliyetlere yönlendirmesi gerektiği değerlendirmesinde bulunan Ergün, konuşmasını şöyle tamamladı:
"2030 hedefleri açısından aslında bu geçecek olan 5 yıllık süreç bizim için çok önemli, kritik bir döneme giriyoruz ve eşik noktalarının aşılmaması için de tüm dünya ülkelerinin kolektif olarak çalışması gerekiyor. Bunun için de tamamen Taraflar Konferansı'nda verilen taahhütlerden elde edilecek sonuçlara tam anlamıyla riayet etmemiz gerekiyor. Bu 5 yılı hem ülkemiz için hem küresel anlamda çok iyi değerlendirmemiz gerekiyor."